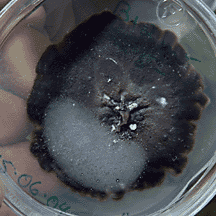

|
|
Le criocère de l'asperge. Les filaments blancs qui entourent la tête de l'insecte sont des champignons Impudentia. |
Certains les dénichent au marché et les aiment sautés, mais lui les découvre dans les boites de Pétri de son laboratoire. Vladimir Vujanovic, chercheur au Département de sciences biologiques et à l’Institut de recherche en biologie végétale (IRBV), est un mycologue découvreur de champignons. Il a à son actif une dizaine de découvertes en autant d’années.
On ne pourra toutefois pas les apprêter dans de nouvelles recettes puisqu’il s’agit de microchampignons, mais ses travaux pourront tout de même contribuer au sauvetage d’au moins une industrie agroalimentaire québécoise, celle de l’asperge.
 |
|
Vladimir Vujanovic |
«Au Québec, 45 % des plantations d’asperges sont en mauvaise santé et 32 % sont très mal en point», affirme le professeur Vujanovic à la lumière des données d’une recherche effectuée dans six régions de la province. La production décroit sans cesse depuis 10 ans et plusieurs producteurs ont abandonné cette culture pourtant très rentable économiquement. Pour se consoler, mentionnons que l’épidémie qui touche ce légume n’est pas propre au Québec mais s’étend sur toute l’Amérique du Nord.
Le responsable en est un champignon microscopique, Fusarium, qui cause la pourriture des racines (la fusariose). Ce champignon est toujours présent dans les aspergeraies, mais la maladie ne se déclare pas forcément», précise le chercheur. En voulant cerner les conditions d’apparition de la fusariose, il a identifié une douzaine d’espèces de Fusarium jamais répertoriées auparavant en association avec l’asperge. Parmi celles-ci, une souche non pathogène pourrait permettre de contrôler la souche virulente, selon des travaux réalisés in vitro à l’IRBV.
 |
|
Illustration du champignon Phialocephala victorinii, une espèce découverte par Vladimir Vujanovic sur des racines d’orchidée et qu’il a nommée ainsi en l’honneur du frère Marie-Victorin. |
Mais la principale découverte de Vladimir Vujanovic dans ce domaine a été de montrer que le criocère de l’asperge, un coléoptère dont la larve s’attaque à la plante, transporte avec lui Fusarium et constitue ainsi un vecteur de la maladie au Québec. Un proche cousin de cet insecte cause le ravage du lys, au grand dam des horticulteurs du Jardin botanique, où la culture de cette fleur est pour ainsi dire en voie d’être abandonnée.
Le mycologue a également découvert que le criocère transporte son propre ennemi mortel, Impudentia. Il s’agit d’un nouveau genre de champignon mis au jour par le professeur Vujanovic et qui peut détruire l’insecte. En laboratoire, les travaux ont démontré que ce champignon nuisait à la reproduction et à la croissance du criocère, ce qui pourrait contribuer à la mise au point de procédés de contrôle biologique de l’insecte et freiner la dissémination de la fusariose.
Ses travaux sur les champs d’asperges ont par ailleurs montré que la fertilisation au phosphore n’améliore aucunement le rendement des aspergeraies et rend même la plante plus vulnérable aux maladies. De plus, le manque de manganèse dans le sol est corrélé avec une prolifération des souches virulentes de Fusarium.
La maladie corticale du hêtre
|
|
Dans cette boite de Pétri, Vladimir Vujanovic a cultivé le champignon Pseudorobillarda monica, qu’il a lui-même mis au jour dans les feuilles d’un tuya bonsaï chinois au Jardin botanique et auquel il a donné le nom de sa femme, Monique. |
Vladimir Vujanovic a par ailleurs identifié 60 microchampignons associés à l’écorce du hêtre et parmi eux quatre espèces nouvellement décrites. Deux de celles-ci, trouvées au Québec, ont été désignées pour la première fois comme des agents de biocontrôle de la maladie corticale du hêtre.
«Cette maladie, qui produit des chancres sur l’écorce du hêtre, est causée par un champignon que transporte un puceron, deux pathogènes exotiques de provenance européenne introduits en Nouvelle-Écosse en 1890, explique le chercheur. La maladie progresse de 20 km par année vers le sud-ouest du continent et elle a déjà eu des effets tragiques sur l’environnement en Amérique du Nord.»
Les envahisseurs ont été repérés il y a quelque temps dans la réserve écologique du Boisé-des-Muir, près de Huntington, sans doute la seule forêt de l’époque précoloniale du sud-est du Québec encore intacte.
Cette forêt emblématique a été le lieu d’une étude comparative entre la biodiversité en milieu naturel et celle en milieu urbain. Les observations de Vladimir Vujanovic et de son collègue Jacques Brisson ont été renversantes: des 36 espèces de microchampignons découvertes dans les feuilles des érables à sucre de la réserve, il n’en subsiste que 6 dans les feuilles de ces mêmes érables cultivés à Montréal.
«Il s’agit de champignons endophytes qui vivent en symbiose avec les cellules de la feuille. On ne connait pas bien leur fonction, mais ils jouent sans doute un rôle dans la défense de l’arbre contre les maladies et les insectes prédateurs en synthétisant des substances métaboliques qui renforcent le système de protection de cet arbre précieux.»
Daniel Baril
| Les champignons ne sont pas des végétaux! |
|
On ne connaitrait actuellement que 5 % des quelque 1,5 million d’espèces de champignons. Et à peine 0,001 % des microchampignons auraient été séquencés. Aussi bien dire qu’on ne fait que commencer à s’intéresser à leur rôle dans la chaine du vivant.
Pour Vladimir Vujanovic, spécialiste des microchampignons, la mycologie mériterait plus d’attention de la part des milieux de la recherche. «Principalement considérée comme un outil, déplore-t-il, la mycologie doit être vue comme un domaine spécifique de recherche en biologie.»
Fait étonnant, les champignons ne sont pas considérés comme faisant partie du règne végétal, quoi qu’en disent les dictionnaires. «En taxonomie, les champignons sont classés dans un règne à part, se situant entre les végétaux et les animaux, indique le spécialiste. Dans l’échelle de l’évolution de la vie terrestre, ils sont apparus il y a environ 450 millions d’années, après les bactéries et avant les végétaux.»
Selon les mycologues, les champignons seraient d’ailleurs biologiquement plus près du règne animal que du règne végétal. D’abord, leur sucre principal, le tréhalose, n’existe pas chez les plantes. Ensuite, leur membrane est composée de chitine, un polysaccharide composant les carapaces d’insectes et de crustacés. Finalement, les relations phylogénétiques établies à partir du séquençage de l’ADN montrent cette surprenante parenté entre champignons et règne animal.
D.B. |